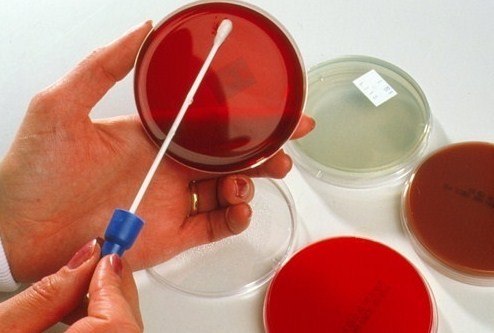
ncUKQIiRn-A

Гонорея – это вторая по распространённости венерическая инфекция после хламидиоза. Ее возбудитель Neisseria gonorrhoeaе поражает преимущественно мочеполовую систему человека, обитая на слизистых оболочках. Чаще всего ее обнаруживают у женщин в молодом возрасте. Болезнь без лечения несет в себе опасность в виде разного рода осложнений и может стать причиной летального исхода из-за гонококкового сепсиса.
Гонорея: пути передачи
Заразиться гонореей можно половым путем посредством любых сношений:
- вагинальным;
- оральным;
- анальным.
Важно: бытовой путь передачи практически не возможен, в виду того что гонококк не живет вне организма дольше, чем 4 часа. Для непосредственного заражения требуется определённое количество самих бактерий, которые бы смогли попасть в конкретный организм, что при бытовом способе не может быть обеспечено. Это исключает заражение гонореей через сидение унитаза, посуду, воду в бассейне, полотенце, баню и другие вещи общего пользования.
При этом часто также встречается заражение новорожденного во время родов через родовые пути матери, что проявляется гонококковым конъюнктивитом.
Обратите внимание: статистика утверждает, что после однократного полового акта с зараженным партнером риск женщины заболеть гонореей становит практически 90%, мужчины же заболевают только в 35% случаев. Такая ситуация объясняется разными физиологическими особенностями строения половой системы женщины и мужчины.
Врачи подчеркивают, что гонорея является одной из наиболее распространенных инфекций, передающихся половым путем. Основные пути передачи инфекции — это незащищенные половые контакты, включая вагинальные, анальные и оральные. Симптомы могут варьироваться: у мужчин это часто болезненное мочеиспускание и выделения из уретры, тогда как у женщин симптомы могут быть менее выраженными, что затрудняет диагностику. Важно отметить, что инфекция может привести к серьезным осложнениям, таким как воспалительные заболевания органов малого таза. Лечение гонореи обычно включает антибиотики, однако врачи предупреждают о растущей устойчивости некоторых штаммов к препаратам. Поэтому своевременная диагностика и лечение являются ключевыми для предотвращения распространения инфекции и ее осложнений.

Гонорея: симптомы
Инкубационный период длится от 3 дней до 1 месяца, но чаще до 2 недель. По типу течения гонорея бывает хронической, когда после заражения прошло более 60 дней, и острой – до 2 месяцев.
Первые признаки гонореи – это симптомы со стороны мочевыделительной системы у обоих полов:
- нарушенное учащенное мочеиспускание, сопровождаемое болью;
- жжение;
- зуд;
- выделения гнойного характера.
Сегодня очень часто гонорея имеет нетипичную клиническую картину из-за того, что она формируется на фоне вторичной инфекции. В данном случае смешанная инфекция несколько изменяет инкубационный период, чем делает проблематичной правильную диагностику и соответственно адекватное лечение гонореи. В итоге очень часто формируется ее хроническая форма, которую уже диагностируют при наличии осложнений.
Гонорея у женщин
Признаки гонореи у женщин могут отсутствовать или иметь общие признаки, что бывает в 70%.
При этом наиболее часто женщина с гонореей предъявляют такие жалобы:
- выделения из влагалища (обильные, густые или водянистые, от белого до зеленого цвета);
- болевой синдром внизу живота;
- кровотечения не связанные с менструальным циклом.
Симптомы гонореи проявляются обычно перед началом месячных. Проявляются они в виде цервицита, вагинита и проктита. Гонококковый цервицит и вагинит выражается выделениями, явлениями дизурии, болями в боку или внизу живота в очень острой форме, что длиться около 10 дней. У каждой 5-й больной женщины наблюдается восходящая инфекция, когда бактерии распространяются вверх по половым органам. Этому способствуют такие причинные факторы как аборт, менструация, внутриматочная спираль, роды. В итоге у пациентки развивается острый эндометрит или сальпингит. Наиболее негативный прогноз после сальпингита – это бесплодие в результате рубцевания фаллопиевых труб, эктопическая или внематочная беременность, невынашивание.
Обратите внимание: при распространении по организму, гонорея может поражать и другие органы: сердце, суставы, кожу, почки, мозг, мышцы, печень, кости, сепсис.
Также наблюдаются общие симптомы гонореи:
- тошнота;
- плохое самочувствие;
- боли в области низа живота;
- жидкий стул;
- субфебрилитет;
- нарушенный менструальный цикл.
Гонорея — это инфекционное заболевание, передающееся преимущественно половым путем. Люди часто обсуждают, как важно знать о путях передачи, чтобы избежать заражения. Основные симптомы включают болезненное мочеиспускание, выделения из половых органов и боль внизу живота. Однако многие не осознают, что гонорея может протекать бессимптомно, что делает её особенно опасной. Лечение обычно включает антибиотики, но важно пройти полный курс, чтобы избежать рецидивов и развития устойчивости к препаратам. Профилактика, включая использование презервативов и регулярные медицинские осмотры, играет ключевую роль в борьбе с этой инфекцией. Обсуждение гонореи помогает развеять мифы и повысить осведомленность о здоровье.

Гонорея у мужчин
Главные симптомы гонореи у сильного пола – это выделения из полового члена (обильные, белого или желтого цвета), которые оставляют следы на белье.
Если болезнь не лечить, то она распространяется восходящим путем и может проникать в яички. Вызывая в них необратимые дегенеративные процессы. Типичная клиника гонореи у мужчин – это острый уретрит. Он проявляется через 2-5 дней после незащищенного полового акта. Мужчина жалуется на расстройства мочеиспускания и выделения. По характеру выделений чаще всего дифференцируют гонорею от хламидиоза, так как вначале они будут слизистыми и необильными, но через день-два переходят в гнойные и их становится намного больше.
Обратите внимание: из-за того, что течение гонореи у мужчин может протекать бессимптомно, они часто становятся источником распространения болезни.
Диагностика
Не смотря на довольно острую симптоматику гонореи, подтвердить ее можно исключительно с помощью лабораторных методов после посещения специалиста. Обследование на гонорею включает такие пункты:
- Осмотр врача. После сбора анамнеза и выяснения жалоб, врач проводит обследование. Гинеколог при бимануальном и зеркальном осмотре определит у женщины воспалительный процесс: гиперемия слизистой влагалища, отечность в области устья уретры, цервицит, обильные выделения гнойного характера.У мужчин венеролог обнаружит признаки уретрита и гнойные выделения.
- Лабораторная диагностика.
Для подтверждения гонореи лабораторными методами используются следующие способы:
- Анализ выделений, взятых из уретры – мазок на гонорею.
- Посев выделений из канала шейки матки, глотки, уретры, прямой кишки, влагалища. Этот анализ наиболее точный и занимает по времени около 7 дней. Именно его чаще всего назначают при подозрении на гонорею у женщин.
- Полимеразная цепная реакция. Это ДНК-диагностика, которая позволяет обнаружить возбудителя в течение 1-2 дней с достоверностью 95%.
Важно: мазок на гонококк позволяет обнаружить болезнь только у 60% женщин, больных гонореей, и у 90% мужчин. В данном случае наиболее информативный способ – это посев выделений или метод ПЦР.

Лечение гонореи
Важно: при подозрении на гонорею крайне опасно заниматься самолечением. Только врач может правильно поставить диагноз и подобрать адекватное лечение. Наиболее частыми осложнениями гонореи является бесплодие и импотенция.
Лечение гонореи заключается в назначении антибиотиков. Препарат подбирают исходя из выраженности симптомов и состояния пациента. Чаще всего побирается представитель группы цефалоспоринов и фторхинолонов.
Успешность лечения гонореи зависит от правильно выбранного антибиотика, дозировки и длительности его приема. При непереносимости антибиотиков назначают сульфаниламиды. Параллельно при необходимости в лечебную схему включают средства иммунотерапии, местные препараты (мази, гели, пасты), а также физиотерапию (УВЧ, ванночки).
Важно не прекращать лечение после наступления облечения, потому что в таком случае гонококк не ликвидируется полностью, а просто переходит в скрытую форму и протекает хронически. При этом у возбудителя может выработаться устойчивость к антибиотикам, из-за чего гонококк становится скрытым, и его намного тяжелее впоследствии правильно диагностировать. После пройденного курса следует обязательно повторно сдать мазок на гонококк.
Врачи также во время лечения рекомендуют придерживаться следующих общих рекомендаций:
- Строгое соблюдение правил личной гигиены.
- Тщательное мытье рук после посещения туалета.
- Придерживаться режима обильного питья во время лечения.
- Мужчинам запрещается выдавливать гной из уретры во избежание распространения гонореи.
- Исключить из ежедневного меню острое и соленое, любой алкоголь.
- Нельзя посещать бассейн.
- Не следует ездить на велосипеде, велотренажере.
- Исключение тяжелых физических нагрузок.
Гонорею у мужчин лечит уролог или венеролог, у женщин – гинеколог.
Обратите внимание: современная медицина вполне способна вылечить гонорею, но при условии, что пациент придерживается всех врачебных рекомендаций, принимает препараты и соблюдет правила личной гигиены.
Профилактика гонореи
Предотвращение гонореи залучается в соблюдении простых, но эффективных методов ее профилактики:
- постоянный половой партнер;
- отказ от случайных половых связей;
- регулярное использование презервативов;
- посещение врача при первых тревожных симптомах.
Более подробную информацию об основных сложностях в лечении гонореи, связанных с мутациями гонококков, симптомах гонореи и мерах профилактики вы получите, просмотрев данный видео-обзор:
Викторова Юлия, акушер-гинеколог
Вопрос-ответ
Чем эффективно лечить гонорею?
Препаратами выбора являются цефтриаксон (раствор для инъекций) и азитромицин (капсулы, таблетки). Лечение гонореи у мужчин и женщин проводят по одной схеме. После курса антибактериальной терапии необходимо еще раз сдать анализ на гонококк. Повторное тестирование рекомендуется через три месяца после лечения.
Как проявляет себя гонорея?
Гонорея чаще всего передается половым путем от инфицированного партнера. Заболевание сопровождается выделениями и болью в органах мочеполовой системы, а также может поражать прямую кишку, носоглотку, глаза, суставы. Патология чаще диагностируется у мужчин.
Каким способом передаётся гонорея?
Как правило, она передается при вагинальном, оральном или анальном сексе. Гонорея поддается лечению и излечивается при помощи антибиотиков. Большинство случаев гонореи можно предотвратить с помощью регулярного и правильного использования презервативов. Симптомы гонореи у женщин и мужчин различаются.
Какие симптомы при гонорее у женщин?
Гнойные или слизисто-гнойные вагинальные или уретральные выделения, болезненность при интимной (вагинальной) близости, жгучие и зудящие ощущения в области вульвы и влагалища, неприятные и болезненные ощущения при опорожнении мочевого пузыря, неинтенсивные боли в нижних отделах живота.
Советы
СОВЕТ №1
Регулярно проходите медицинские обследования, особенно если у вас есть несколько половых партнеров. Это поможет выявить инфекцию на ранней стадии и предотвратить ее распространение.
СОВЕТ №2
Используйте барьерные методы контрацепции, такие как презервативы, чтобы снизить риск передачи гонореи и других половых инфекций. Это особенно важно при случайных половых контактах.
СОВЕТ №3
Обратите внимание на симптомы гонореи, такие как болезненное мочеиспускание, выделения из половых органов и боль внизу живота. При появлении этих признаков немедленно обратитесь к врачу для диагностики и лечения.
СОВЕТ №4
Если вы узнали о своем диагнозе, обязательно уведомите всех своих половых партнеров, чтобы они также могли пройти обследование и лечение. Это поможет предотвратить дальнейшее распространение инфекции.